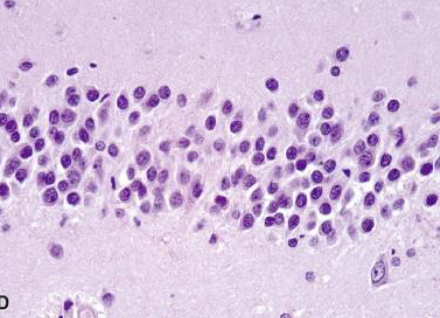

What is unique about the CNS? (3)
Selective vulnerability of neuronal systems
Mature neurons are post-mitotic cells
Unique anatomic/physiologic characteristics
What are some unique anatomic/physiolgic characteristics of the CNS? (6)
Normal neurons are integrating & transmitting cells of the CNS, using _______ & _______ means.
Morphology varies by ______.
chemical & electrical
location
What is unique about the nucleus of normal neurons?
Where are these neurons located?
What type of cell is this?

Anterior horn cells (motor neuron)
What type of cell is this?

Cerebral cortex neurons
Pyramidal shape
What type of cell is this?

Neuromelanin-containing neurons in brainstem
Substantia nigra, locus ceruleus, motor nucleus of vagus
What type of cell is this?
Granular neurons of the dentate fascia of the hippocampal formation
What type of cell is this?

Purkinje cells & granular cells of the cerebellar cortex
_______ accumulates in neuronal cytoplasm w/ age.
Lipofuscin

Cerebral neocortex (isocortex) contains ____ layers, numbered sequentially from ______ to _______.
6 layers
superficial to deep

What is this?

What are the reactions of neurons to injury? (3)
Eosinophilic Degeneration
Definition
Morphologic criteria

What is this?

Scattered acutely hypoxic/ischemic neurons
(Eosinophilic Degeneration)
Central Chromatolysis
Definition
Reversible or Irreversible?
Histology

What are the 2 types of glial cells of the CNS?
Astrocytes
Characteristics
Components

Astrocytes
Function (4)

What are reactive astrocytes?

Oligodendroglia
Definition
Characteristics

What are 3 important diseases involving oligodendrocytes?
Ependymal cells (Ependyma)
Characteristics
